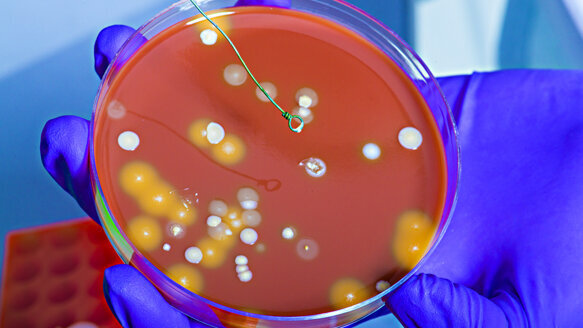
Study: Bib clips can harbor bacteria even after disinfection

CAMBRIDGE, Mass., USA: Researchers at Tufts University School of Dental Medicine and the Forsyth Institute have published a study that found a significant proportion of dental bib clips harbored bacteria from the patient, dental clinician and the environment even after the clips had undergone standard disinfection procedures in a hygiene clinic.
Although the majority of the thousands of bacteria found on the bib clips immediately after treatment were adequately eliminated through the disinfection procedure, the researchers found that 40 percent of the bib clips tested post-disinfection retained one or more aerobic bacteria, which can survive and grow in oxygenated environments. They found that 70 percent of bib clips tested post-disinfection retained one or more anaerobic bacteria, which do not live or grow in the presence of oxygen.
The full study, titled “Comprehensive Analysis of Aerobic and Anaerobic Bacteria Found on Dental Bib Clips at Hygiene Clinic,” is being published as a supplement to the April issue of Compendium of Continuing Education in Dentistry, and is available for download at www.dentalbibclipbacteria.com.
“The study of bib clips from the hygiene clinic demonstrates that with the current disinfection protocol, specific aerobic and anaerobic bacteria can remain viable on the surfaces of bib clips immediately after disinfection,” said Addy Alt-Holland, M.Sc., Ph.D., assistant professor at the Department of Endodontics at Tufts University School of Dental Medicine and the lead researcher on the study. “Although actual transmission to patients was not demonstrated, some of the ubiquitous bacteria found may potentially become opportunistic pathogens in appropriate physical conditions, such as in susceptible patients or clinicians.”
The study analyzed the clips on 20 dental bib holders after they had been used on patients treated in a dental hygiene clinic. The bib clips were sampled for aerobic and anaerobic bacterial contaminants immediately after treatment (post-treatment clips) and again after the clips were cleaned using disinfecting, alcohol-containing wipes (post-disinfection clips) according to the manufacturer instructions and the clinic’s disinfection protocol.
Led by Dr. Bruce Paster, chair of the Department of Microbiology at the Forsyth Institute, microbiologists at the Forsyth Institute used standard molecular identification techniques and a proprietary, one-of-a-kind technology that can detect 300 of the most prevalent oral bacteria, to analyze the sampled bacteria from the bib clips. The analyses found:
- Immediately after treatment and before the clips had been disinfected, oral bacteria often associated with chronic and refractory periodontitis were found on 65 percent of the clips.
- After disinfection, three of the bib clips (15 percent) still had anaerobic Streptococcus bacteria from the oral cavity and upper respiratory tract. Five percent of the clips still harbored at least one bacteria from the Staphylococcus, Prevotella and Neisseria species.
- Additionally, after disinfection, nine clips (45 percent) retained at least one anaerobic bacterial isolate from skin.
“The results of our analysis show that there is indeed a risk of cross-contamination from dental bib clips. The previous patient’s oral bacteria could potentially still be on the clip and the new patient has a chance of being exposed to infection by using that same bib clip,” Paster said. “It is important to the clinician and the patient that the dental environment be as sterile as possible; thus it’s concerning that we found bacteria on the clips after disinfection. This situation can be avoided by thoroughly sterilizing the clips between each patient or by using disposable bib holders.”
Researchers involved in the study hypothesized that bacteria found on bib clips after patient care could have been transferred from patients and clinicians to the clips in different ways:
- Oral bacteria present in the patient’s saliva and the spray or spatter produced during dental treatments may contribute to the presence of bacteria on the disinfected bib clips.
- Bacteria can also be transferred from the gloved hands of dental practitioners to the clips prior to or during the patient’s treatment.
- Bacteria can be transferred from the patient’s hands to the clips if the patient touches the clip.
In a previous study published in August 2012 by researchers at Tufts University School of Dental Medicine and the Forsyth Institute, it was found that 20 to 30 percent of dental bib clips still harbor aerobic bacterial contaminants even after proper disinfection procedures. Rubber-faced metal bib clips were found to retain more bacteria than bib clips made only of metal immediately after treatment and before disinfection.
Four other research reports have found bacterial contamination on dental bib holders, including research conducted by U.S. infection control specialist Dr. John Molinari, the University of North Carolina at Chapel Hill’s School of Dentistry Oral Microbiology lab and the University of Witten/Herdecke in Germany.
(Source: Forsyth Institute)
OXNARD, Calif., USA: Researchers at Tufts University School of Dental Medicine, in collaboration with researchers at the Forsyth Institute, have published a...
CHICAGO: Research has shown that playing a musical instrument can help nourish, cultivate and increase intelligence in children, but playing a used ...
CHICAGO, Ill., USA: Parents should be aware that bacteria that cause dental decay can be transmitted from adult to child by sharing eating utensils, or by ...
OXNARD, Calif., USA: A recent report authored by John A. Molinari, Ph.D., and Peri Nelson, B.S., suggests that there are many advantages of using disposable...
NEW YORK, NY, USA: Dr Deepak Saxena, a microbiologist at the New York University College of Dentistry (NYUCD), and Dr Anup Singh, an engineer at Sandia ...
The American Dental Association (ADA) has announced that its annual SmileCon conference will hold its final event in October 2025.
PHILADELPHIA, US: It was previously believed that Streptococcus mutans was the main microorganism responsible for dental caries. However, in a recent study,...
ChairsideCAD, available from exocad, is the choice of software for leading manufacturers of dental CAD/CAM systems, according to the company, and it has ...
BUFFALO, N.Y., USA: Researchers at the University at Buffalo have received a $239,000 grant from the National Institute of Dental and Craniofacial Research ...
Botox therapy can provide significant relief with only a mild risk for negative effects to patients with stubborn pain in the muscles involved in chewing, ...
Live webinar
Thu. 2 July 2026
11:00 AM EST (New York)
Dr. Albéric Santamaria-Loisy
Live webinar
Thu. 2 July 2026
2:00 PM EST (New York)
Live webinar
Mon. 6 July 2026
12:00 PM EST (New York)
Live webinar
Tue. 7 July 2026
8:00 PM EST (New York)
Dr. Mark Donaldson BSP, ACPR, PHARMD, FASHP, FACHE
Live webinar
Wed. 8 July 2026
8:00 AM EST (New York)
Live webinar
Wed. 8 July 2026
1:00 PM EST (New York)
Prof. Gianluca Gambarini MD, DDS
Live webinar
Wed. 8 July 2026
10:00 PM EST (New York)
Dr. Jae Seon Kim DDS, MSD, FACP, CDT



 Austria / Österreich
Austria / Österreich
 Bosnia and Herzegovina / Босна и Херцеговина
Bosnia and Herzegovina / Босна и Херцеговина
 Bulgaria / България
Bulgaria / България
 Croatia / Hrvatska
Croatia / Hrvatska
 Czech Republic & Slovakia / Česká republika & Slovensko
Czech Republic & Slovakia / Česká republika & Slovensko
 France / France
France / France
 Germany / Deutschland
Germany / Deutschland
 Greece / ΕΛΛΑΔΑ
Greece / ΕΛΛΑΔΑ
 Hungary / Hungary
Hungary / Hungary
 Italy / Italia
Italy / Italia
 Netherlands / Nederland
Netherlands / Nederland
 Nordic / Nordic
Nordic / Nordic
 Poland / Polska
Poland / Polska
 Portugal / Portugal
Portugal / Portugal
 Romania & Moldova / România & Moldova
Romania & Moldova / România & Moldova
 Slovenia / Slovenija
Slovenia / Slovenija
 Serbia & Montenegro / Србија и Црна Гора
Serbia & Montenegro / Србија и Црна Гора
 Spain / España
Spain / España
 Switzerland / Schweiz
Switzerland / Schweiz
 Turkey / Türkiye
Turkey / Türkiye
 UK & Ireland / UK & Ireland
UK & Ireland / UK & Ireland
 International / International
International / International
 Brazil / Brasil
Brazil / Brasil
 Canada / Canada
Canada / Canada
 Latin America / Latinoamérica
Latin America / Latinoamérica
 China / 中国
China / 中国
 India / भारत गणराज्य
India / भारत गणराज्य
 Pakistan / Pākistān
Pakistan / Pākistān
 Vietnam / Việt Nam
Vietnam / Việt Nam
 ASEAN / ASEAN
ASEAN / ASEAN
 Israel / מְדִינַת יִשְׂרָאֵל
Israel / מְדִינַת יִשְׂרָאֵל
 Algeria, Morocco & Tunisia / الجزائر والمغرب وتونس
Algeria, Morocco & Tunisia / الجزائر والمغرب وتونس
 Middle East / Middle East
Middle East / Middle East

To post a reply please login or register